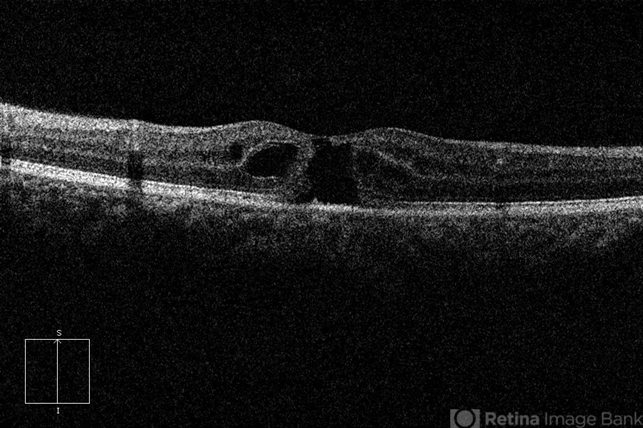

-
 By Young Hee Yoon, MD, PhD
By Young Hee Yoon, MD, PhD
Asan Medical Center
Co-author(s): Dong Hoon Lee, MD, Asan Medical Center - Uploaded on Aug 30, 2012.
- Last modified by Young Hee Yoon, MD, PhD on Aug 30, 2012.
- Rating
- Appears in
- Tamoxifen Retinopathy
- Condition/keywords
- drug toxicity, toxic maculopathy
- Photographer
- Soon Tae Kim, Asan Medical Center
- Imaging device
-
Optical coherence tomography system
Zeiss cirrus HD-OCT 4000 - Description
- OCT image of an 58-year-old woman with a bilateral tamoxifen maculopathy. She had taken tamoxifen for 24 months due to breast cancer. In spite of discontinuation 2 years ago, her macula remained unchanged. Her best-corrected visual acuity was 20/50 in the right and 20/100 in the left.

Initializing download.
Initializing download.

---thumb.jpg/image-square;max$79,0.ImageHandler)
---thumb.jpg/image-square;max$79,0.ImageHandler)
---thumb.jpg/image-square;max$79,0.ImageHandler)


---thumb.jpg/image-square;max$79,0.ImageHandler)
---thumb.jpg/image-square;max$79,0.ImageHandler)
---thumb.jpg/image-square;max$79,0.ImageHandler)
---thumb.jpg/image-square;max$79,0.ImageHandler)
---thumb.jpg/image-square;max$79,0.ImageHandler)